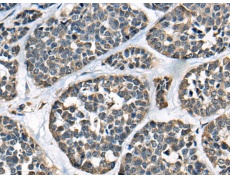
一抗

|
Background: |
This gene encodes a member of the KLHL (Kelch-like) family of proteins. This protein has been identified as an autoantigen in the autoimmune disease Sjogren's syndrome and as a potential biomarker in primary biliary cirrhosis. This protein may act as a substrate adaptor of the Cullin-3 ubiquitin ligase complex to promote substrate-specific ubiquitylation. Ubiquitylation by this complex has been shown to regulate the Wnt signaling pathway as well as COPII vesicle coat size. A pseudogene has been identified on chromosome 22. Alternative splicing results in multiple transcript variants. |
|
Applications: |
ELISA, IHC |
|
Name of antibody: |
KLHL12 |
|
Immunogen: |
Fusion protein of human KLHL12 |
|
Full name: |
kelch like family member 12 |
|
Synonyms: |
DKIR; C3IP1 |
|
SwissProt: |
Q53G59 |
|
ELISA Recommended dilution: |
5000-10000 |
|
IHC positive control: |
Human esophagus cancer |
|
IHC Recommend dilution: |
20-100 |

 購物車
購物車 幫助
幫助
 021-54845833/15800441009
021-54845833/15800441009